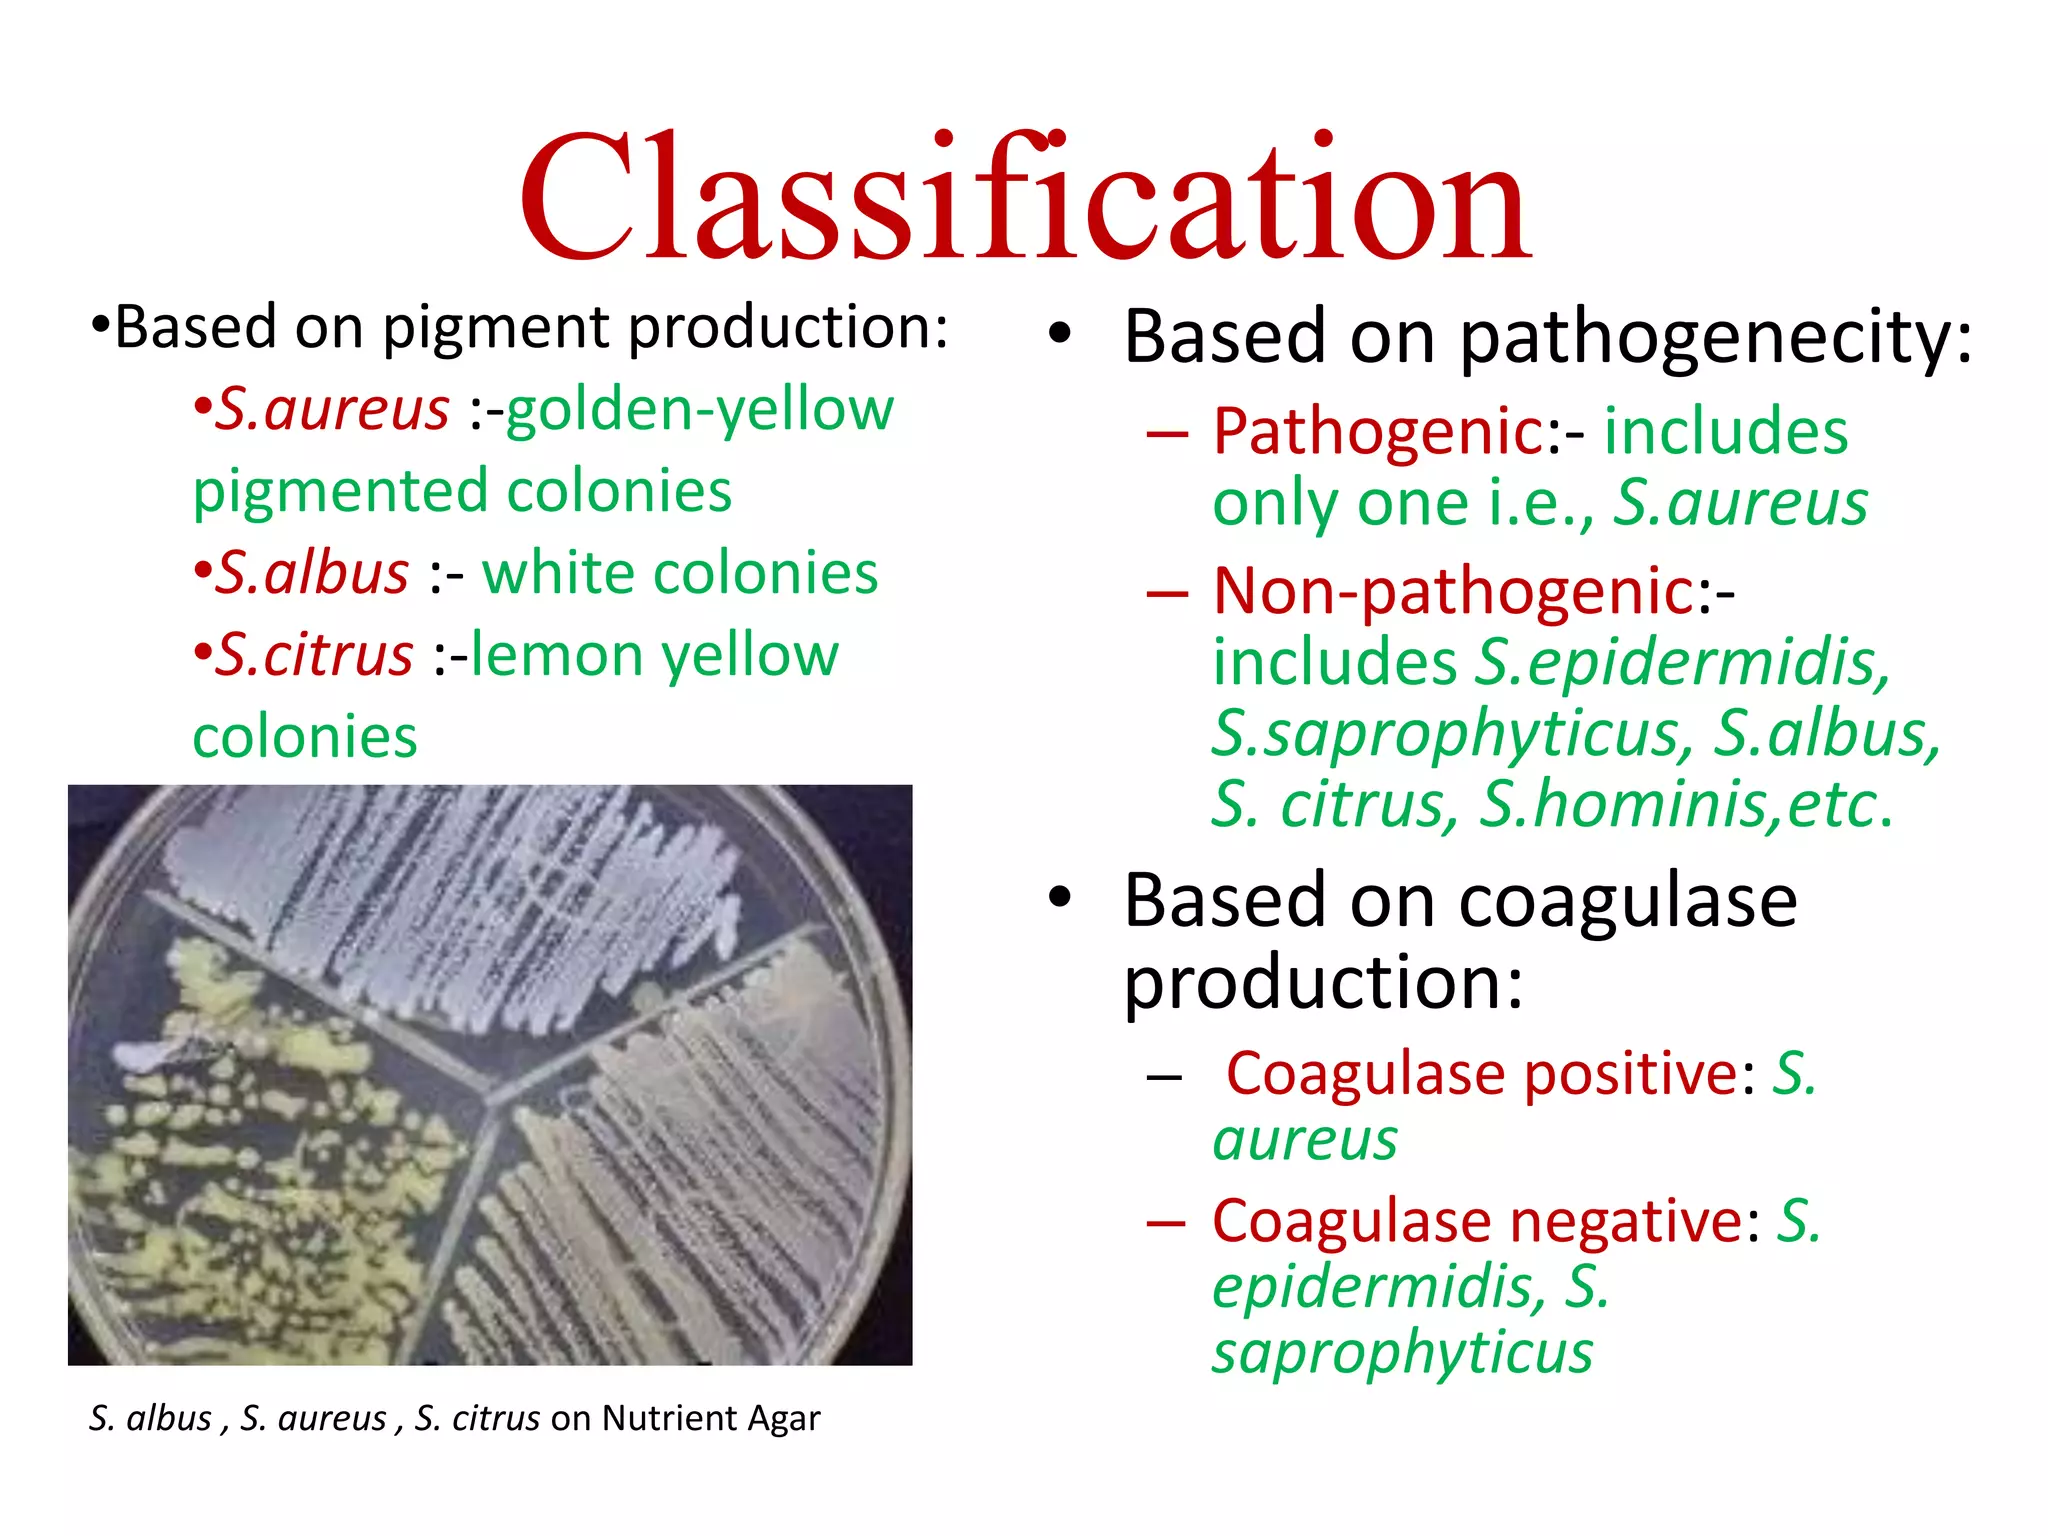
Classification
• Based on pathogenecity:
– Pathogenic:- includes
only one i.e., S.aureus
– Non-pathogenic:-
includes S.epidermidis,
S.saprophyticus, S.albus,
S. citrus, S.hominis,etc.
• Based on coagulase
production:
– Coagulase positive: S.
aureus
– Coagulase negative: S.
epidermidis, S.
saprophyticus
S. albus , S. aureus , S. citrus on Nutrient Agar
•Based on pigment production:
•S.aureus :-golden-yellow
pigmented colonies
•S.albus :- white colonies
•S.citrus :-lemon yellow
colonies
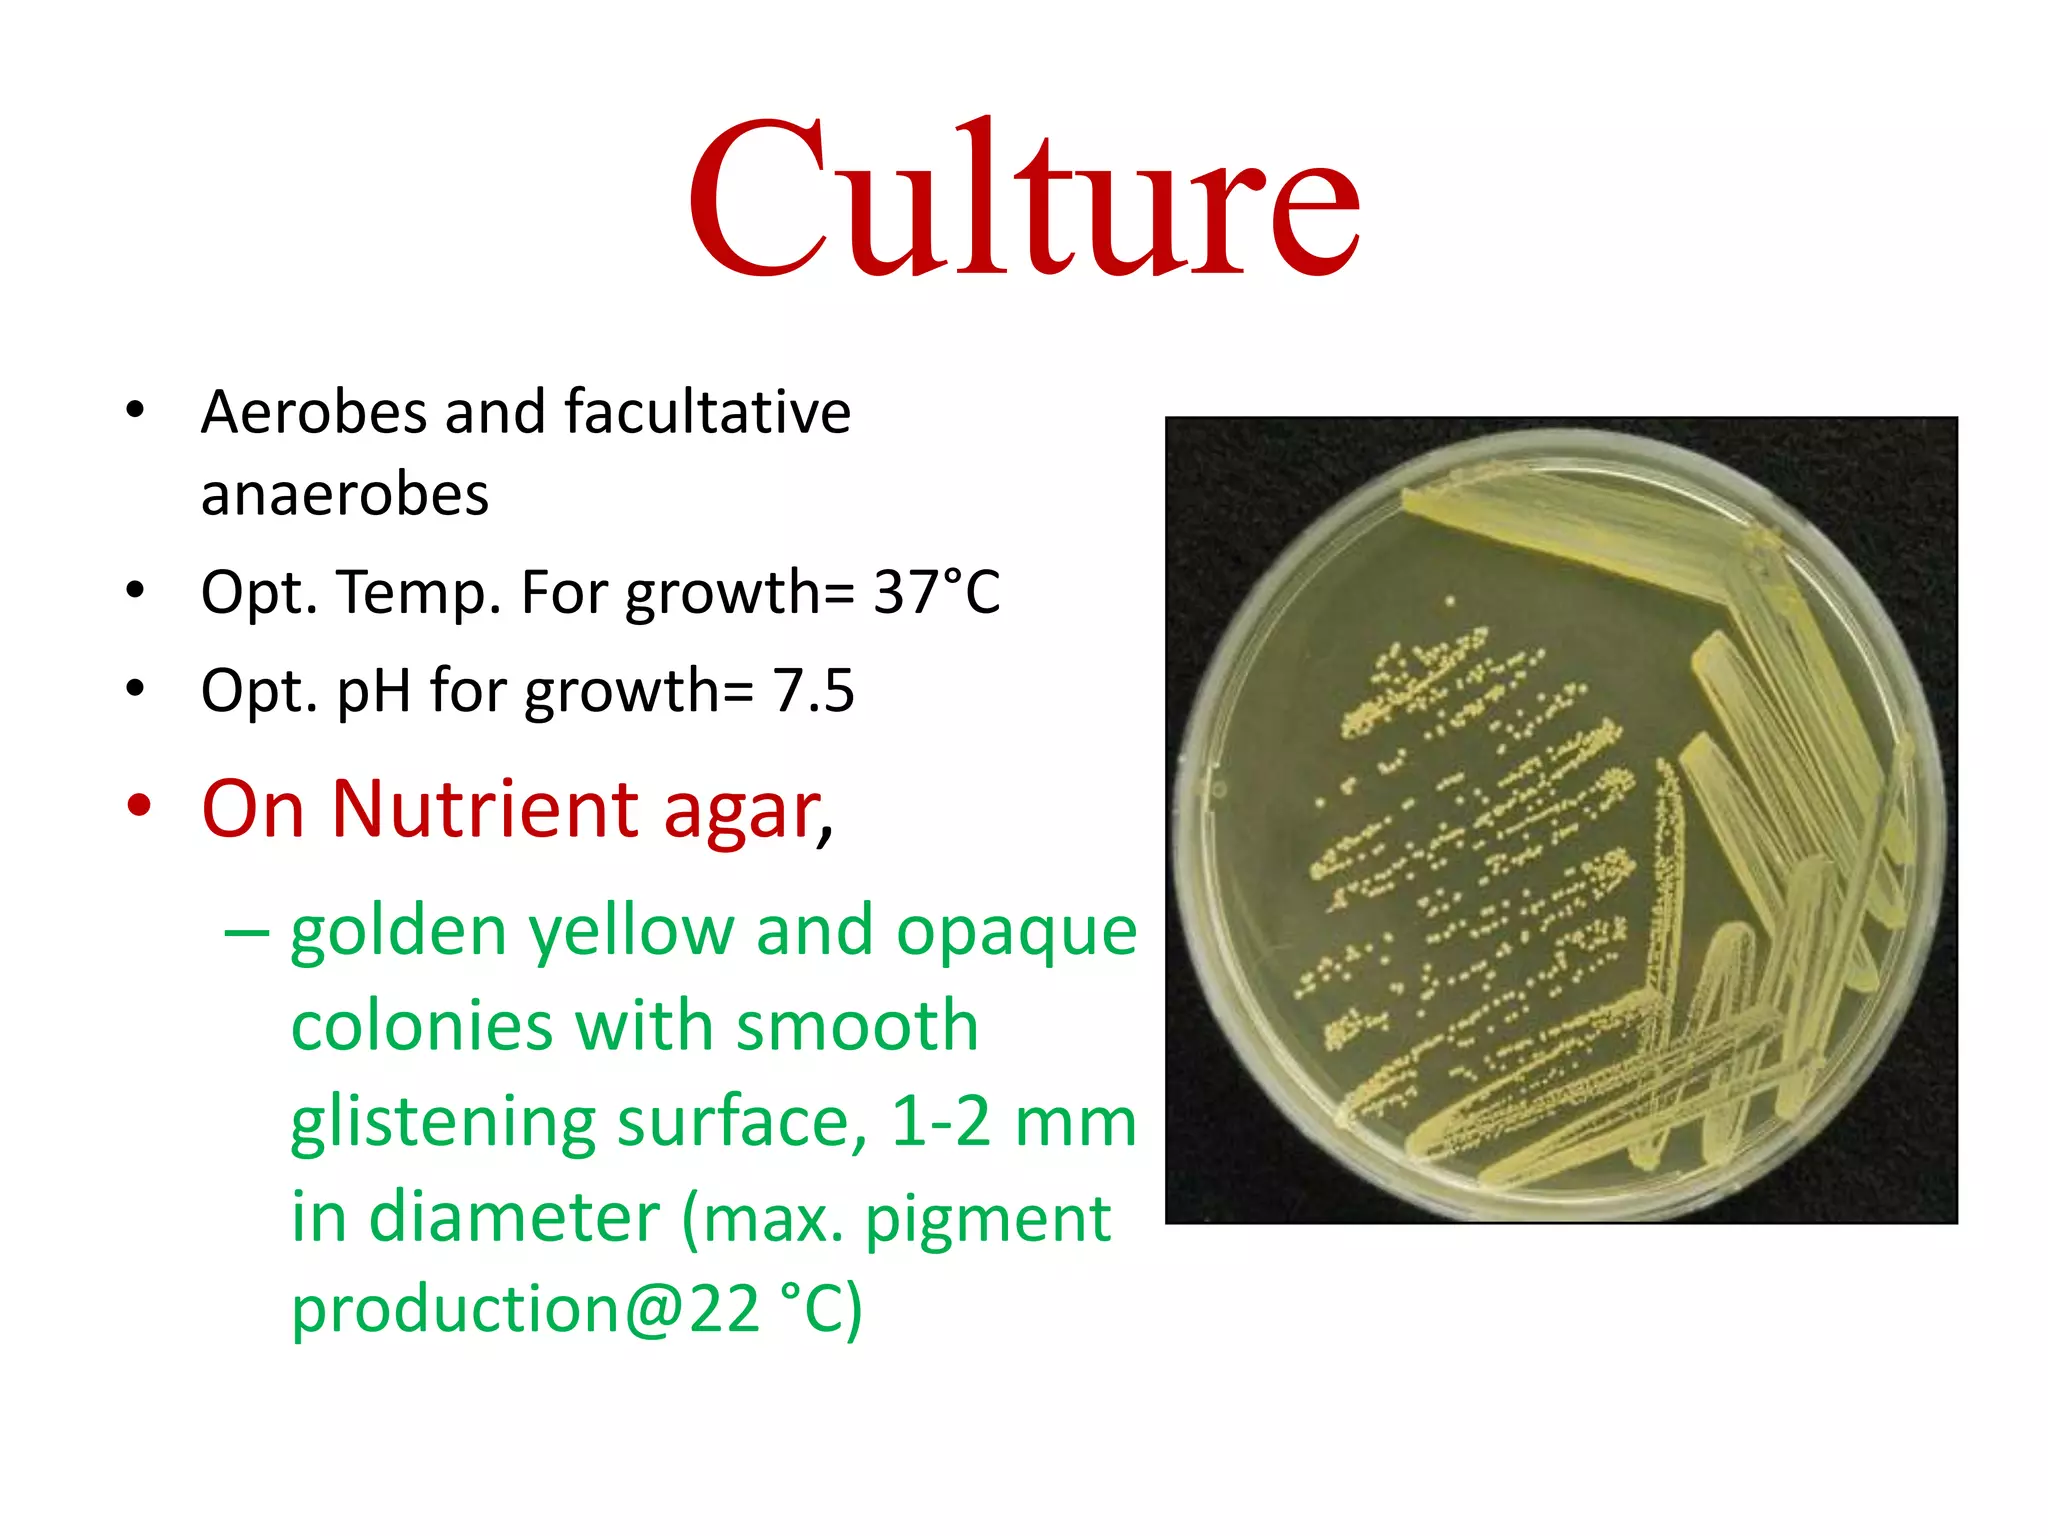
Culture
• Aerobes and facultative
anaerobes
• Opt. Temp. For growth= 37°C
• Opt. pH for growth= 7.5
• On Nutrient agar,
– golden yellow and opaque
colonies with smooth
glistening surface, 1-2 mm
in diameter (max. pigment
production@22 °C)
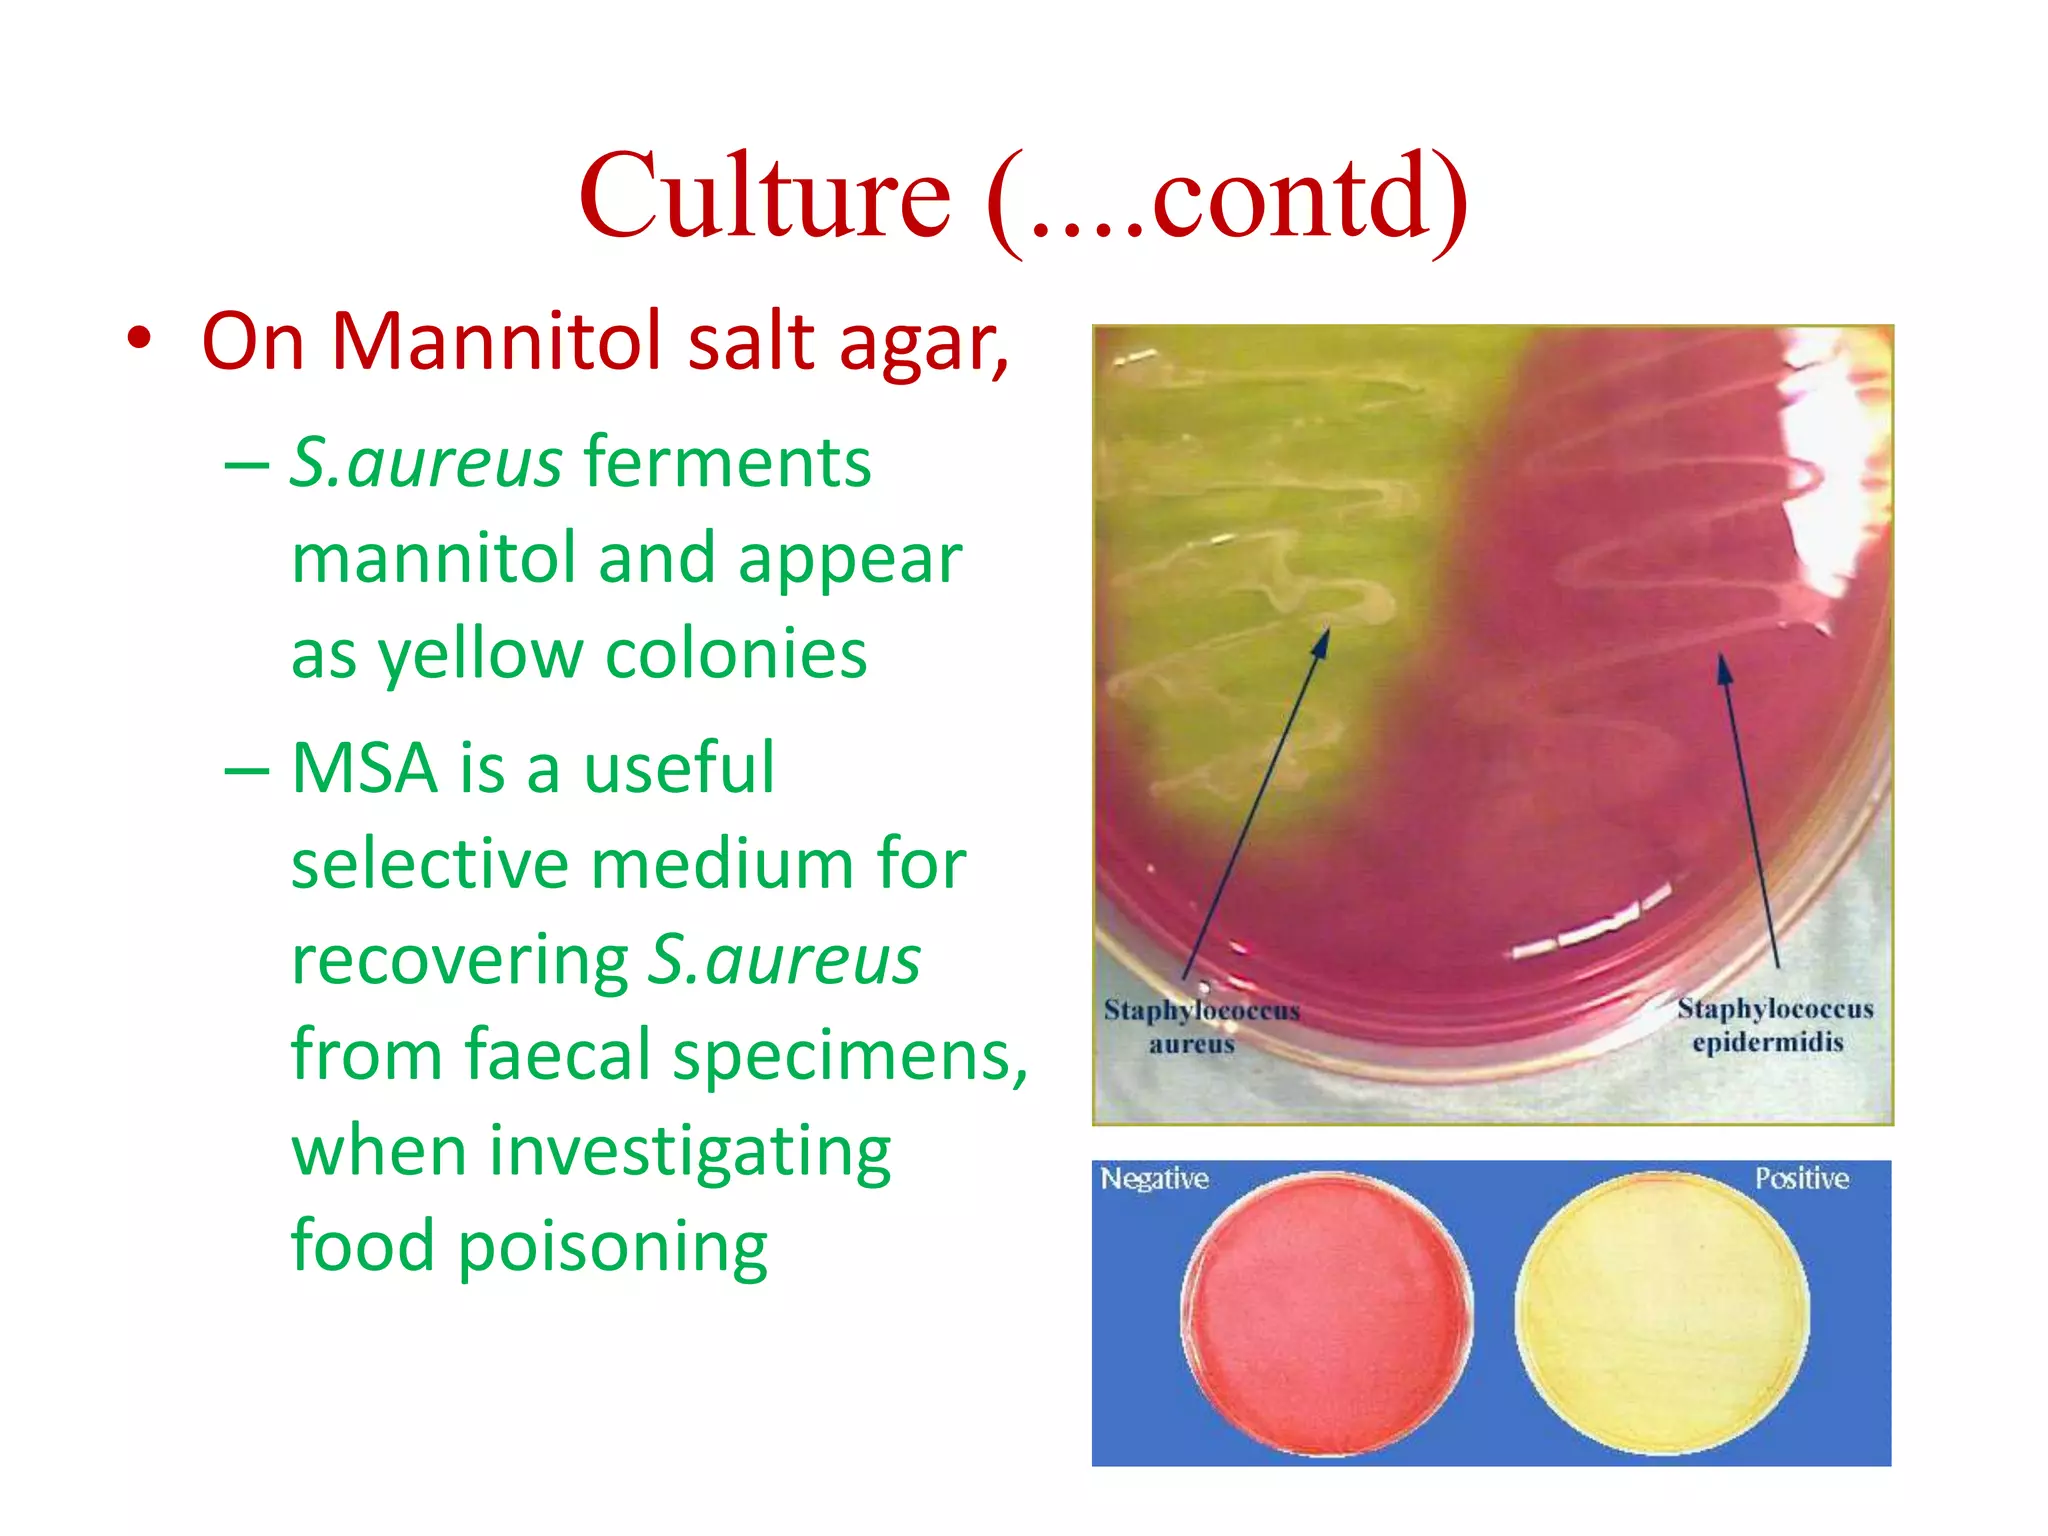
Culture (....contd)
• On Mannitol salt agar,
– S.aureus ferments
mannitol and appear
as yellow colonies
– MSA is a useful
selective medium for
recovering S.aureus
from faecal specimens,
when investigating
food poisoning

Staphylococcus is a genus of bacteria that can cause a variety of infections in humans. The most common pathogenic species is Staphylococcus aureus, which was first identified in the late 19th century. S. aureus produces toxins and enzymes that allow it to infect skin, blood, lungs, and other tissues. It commonly causes skin infections like boils and abscesses but can also lead to serious diseases like pneumonia, meningitis, or toxic shock syndrome. Methicillin-resistant S. aureus (MRSA) infections are difficult to treat with many antibiotics. Laboratory tests are used to identify S. aureus from patient samples and test for antibiotic resistance.

![Laboratory Diagnosis (contd....)
B. Bacteriological
Investigation:
• Specimens:
– Pus: from wound or
abscess or burns]
– Nasal Swab: from
suspected carrier
– Food: to diagnose
staphylococcal intoxication
– Blood: to diagnose
endocarditis and
bacteremia
– Sputum: to diagnose lower
respiratory tract infection](https://image.slidesharecdn.com/staphylococcus-230928081257-d470d800/75/staphylococcus-pdf-32-2048.jpg)



